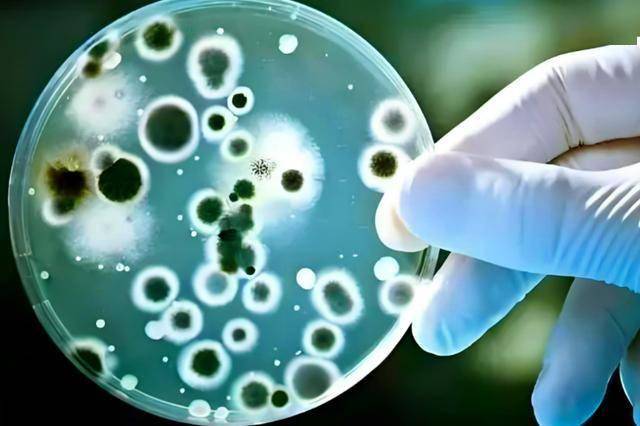

“医生,我爸刚确诊肝癌,昨天体检报告出来,我妈和我,肝上也都有问题……”消化内科门诊里,小李一边说一边哽咽。一家三口,常年身体都算“硬朗”,很少感冒住院。唯一的习惯,就是“什么都往冰箱塞”。
剩菜舍不得倒、切开的水果留着明天吃、开封没吃完的坚果和腊肉统统冷藏。起初,只有爸爸觉得晚上总是反酸、乏力,挂了个号准备开点胃药。结果一查肝功能异常、B超可疑,进一步检查竟然是肝癌。

医生听说他们家“冰箱里啥都有,常吃剩菜、腊肉、隔夜菜”,脸色一下严肃起来,让全家都做了肝脏筛查——妈妈查出肝硬化,小李有脂肪肝和肝功能异常。
“冰箱不是保鲜的吗?怎么反成了‘肝病帮凶’?”很多人都和小李一样,一边把健康寄托在“有冰箱”,一边忽视了里面“藏着的风险”。
那到底是哪几样东西,长期放在冰箱、吃着吃着就把肝“拖垮”了?家里冰箱,真有可能成为肝癌的隐形推手吗?下面这三类,很多家庭每天都在吃。
先说清楚一点:不是冰箱致癌,而是“放错东西、放太久、放不对”增加了风险。
肝脏是人体最大的“解毒工厂”,吃进嘴里的变质食物、霉变毒素、过量盐脂,最后都要它来收拾残局。

研究显示,约80%~90%的原发性肝癌与乙肝丙肝、黄曲霉毒素、长期饮酒、脂肪肝等危险因素有关,而饮食中霉变食物、反复加热高盐高脂食物,正是其中重要一环。
冰箱只能减缓细菌繁殖,却不能杀菌,更不能“冻死”黄曲霉毒素。一旦食物已经受到污染,就算放进冰箱,毒素依然存在,吃进去,肝就要“硬扛”。
经常在冰箱放这3物,一家三口的肝都受不了
坚持这种“冰箱习惯”几年下来,肝脏可能悄悄发生多种变化,很多人等到体检查出来,已经错过了最佳干预期。
发霉或接近变质的坚果、玉米、米面
花生、核桃、瓜子、玉米、米面等,一旦受潮发霉,就极容易产生黄曲霉毒素。这种毒素被世界卫生组织列为Ⅰ类致癌物,对肝脏的毒性非常强,耐高温,100℃以上也很难完全破坏。

很多人以为:“有点霉味丢进冰箱就好了。”其实,一旦霉了,就该直接丢。冰箱只是让你“看不太出来”而已。长期少量摄入黄曲霉毒素,会让肝细胞不断受损、修复,时间一长,容易从慢性肝炎→肝硬化→肝癌,这也是很多“无症状”的人突然确诊肝癌的原因之一。
反复存放、反复加热的荤菜、汤菜
很多家庭晚餐吃不完,就把红烧肉、带鱼、牛肉汤、火锅底料全都装盒冰进冰箱,第二天、第三天继续热来吃。
问题在于:冷藏只能减缓细菌繁殖,并不能阻止细菌和毒素的累积;反复加热,会让食物中的脂肪氧化,产生氧化脂质、杂环胺、多环芳香烃等有害物质;这些物质进入体内,需要肝脏去代谢、解毒,增加肝的负担。
研究发现,长期高脂、高盐、反复油炸和加热的饮食,会让脂肪肝、肝炎、肝纤维化的风险明显上升。尤其是中老年人,肝细胞再生能力本就下降,更经不起这样的“折腾”。
长期腌制、烟熏的肉类:腊肉、腊肠、腌鱼
“吃不完先腌着、熏着,再放冰箱慢慢吃”,是很多家庭的常态。腊肉、香肠、咸鱼本身就含有高盐、亚硝酸盐,在储存、制作、加热过程中,还可能产生亚硝胺类致癌物。
如果再放在冰箱里存很久,拿出来切片炒、煮、煎,多次加热之后,有害物质进一步增加,肝脏要不断处理这些毒素,长年累月,同样会增加肝硬化、肝癌风险。
想护肝,可以这样用冰箱,而不是被它“坑”
冰箱用对了,是帮手;用错了,真可能成“肝病推手”。与其恐慌,不如从今天开始调整习惯。

控制“进冰箱”的量和时间
做饭尽量现吃现做,每餐控制分量,减少“必然剩菜”。熟食在室温下不宜超过2小时,要吃的尽快冷却后冷藏,一般不建议超过24小时就该吃完。任何发霉、异味、颜色明显变化的坚果、粮食、米面,不要“心疼”,直接丢掉。
分类收纳,标日期,定期清冰箱
生熟分开存放,熟食封闭保存,避免交叉污染。冰箱里放东西时,可以贴上日期标签,超过预定时间还没吃完,就坚决处理掉。至少每月彻底清理一次冰箱,发现角落里遗忘的食物,宁可倒掉也不要心疼。

少吃腌制烟熏,学会“减量替代”
腊肉、腊肠、咸鱼、熏鱼等,偶尔尝鲜可以,别当日常菜,尤其有慢性肝病、脂肪肝的人,更要控制。想吃肉,可以多选择新鲜瘦肉、鱼、鸡胸等,清蒸、炖煮的烹饪方式,对肝脏更友好。平时多吃新鲜蔬菜、水果,搭配粗粮、豆类,有助于减轻肝脏代谢压力。
关注自身肝脏“预警信号”
如果长期有乏力、食欲差、右上腹隐痛、脸色蜡黄、蜘蛛痣、腹围变大等情况,尤其本身有乙肝、丙肝、脂肪肝、长期饮酒史,更要提高警惕,及时去医院做肝功能、乙肝两对半、B超等检查。

健康,很多时候并不是“哪一次吃坏了”,而是长期一点点透支的结果。冰箱本身并不可怕,可怕的是:明明有条件吃更新鲜的食物,却总舍不得倒掉“可能已经伤肝”的剩菜和霉食。
如果你家冰箱里,也长期堆着腊肉、发霉坚果、几天的剩菜汤,不妨今天就花十分钟,认真清理一次,从扔掉它们开始,给自己和家人的肝,留一条更安全的路。
本文为健康知识科普,结合权威资料和个人观点撰写,部分情节为方便表达和阅读理解进行了适当虚构与润色,内容仅供参考,不能替代医生诊断。如感不适,请及时就医。收藏以备不时之需,转发给你关心的人!
参考资料:
《中国居民膳食指南(2022)》中国营养学会
《原发性肝癌诊疗规范(2022年版)》国家卫生健康委
《食物中亚硝酸盐与消化道肿瘤风险》中华预防医学杂志
《家庭冰箱使用卫生指南》中国疾控中心营养与健康所科普资料